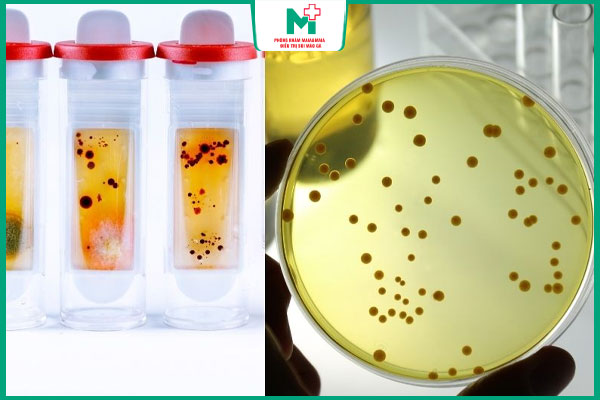
ý nghĩa kết quả rpr

Xét nghiệm giang mai RPR được áp dụng phổ biến hiện nay. Tuy nhiên không phải ai cũng nắm rõ được mục đích cũng như ý nghĩa của phương pháp xét nghiệm này. Cùng tìm hiểu thêm về phương pháp PRP qua bài viết dưới đây của Phòng khám Maia&Maia.
I. Xét nghiệm giang mai RPR là gì?
Xét nghiệm giang mai RPR (Rapid Plasma Reagin) là phương pháp phát hiện kháng nguyên kháng treponemal ở trong máu, chẩn đoán nguy cơ mắc giang mai ở người bệnh. Phương pháp được dùng nhằm xác định được lượng kháng thể xoắn khuẩn giang mai ở bên trong cơ thể, dịch não tủy hoặc nước ối (với phụ nữ mang thai).
Cơ chế của phương pháp xét nghiệm này rất đơn giản. Khi mắc giang mai, cơ thể sẽ sản sinh ra những kháng thể tự nhiên chống lại vi khuẩn lạ gây bệnh. Xét nghiệm RPR sẽ phát hiện các kháng thể này và xác định được tình trạng nhiễm giang mai.

II. Khi nào cần làm xét nghiệm RPR?
Không phải trường hợp nào cũng làm xét nghiệm giang mai RPR, những trường hợp thường được chỉ định làm xét nghiệm này đó là:
- Sàng lọc bệnh giang mai sớm để các bác sĩ có chỉ định điều trị kịp thời
- Theo dõi quá trình và hiệu quả điều trị bệnh giang mai
- Xét nghiệm phát hiện những biến chứng nguy hiểm do giang mai gây ra ở những vị trí khác trên cơ thể như tim, mắt, não, da.
THÔNG TIN LIÊN QUAN: Xét nghiệm giang mai bằng TPHA là gì?
III. Quy trình xét nghiệm RPR chẩn đoán giang mai
Xét nghiệm giang mai RPR là phương pháp có quy trình đơn giản, được thực hiện với những bước như sau:
- Bước 1: Thu mẫu máu: Mẫu máu được lấy từ tĩnh mạch của người bệnh để mang đi xét nghiệm.
- Bước 2: Xử lý mẫu máu: Đưa mẫu máu của người bệnh vào từng ống hít có chứa các chất chống đông máu, sau đó các mẫu máu này sẽ được gửi vào phòng xét nghiệm.
- Bước 3: Tiến hành xét nghiệm: Mẫu máu sẽ được đưa vào những ống thử có chứa chất dùng xét nghiệm RPR.
- Bước 4: Nhận kết quả: Xem xét quá trình kết tủa trong ống thử, nếu có kết tủa tức là trong mẫu máu có kháng nguyên kháng treponemal và là dương tính (mắc bệnh), còn ngược lại là âm tính (không mắc bệnh).

IV. Ý nghĩa của kết quả xét nghiệm RPR
Việc nắm được ý nghĩa kết quả xét nghiệm RPR sẽ giúp mọi người hiểu rõ hơn về tình trạng bệnh lý. Dưới đây là chi tiết ý nghĩa của kết quả xét nghiệm RPR:
1. Âm tính
Kết quả âm tính là không có kháng thể reagin thường xuất hiện khi bị giang mai. Tuy nhiên âm tính sau khi xét nghiệm RPR sẽ không loại bỏ hoàn toàn được nguy cơ mắc giang mai, đặc biệt là nếu ở giai đoạn mới nhiễm bệnh hoặc ở giai đoạn bệnh muộn.
2. Dương tính
Kết quả dương tính cho thấy trong máu có lượng kháng thể reagin, nguy cơ cao mắc giang mai hoặc đã từng mắc bệnh này. Sau khi làm xét nghiệm RPR nếu kết quả là dương tính sẽ cần làm thêm những xét nghiệm chuyên biệt khác để chẩn đoán chính xác tình trạng bệnh. Lý do là bởi RPR chỉ là phương pháp xét nghiệm sàng lọc giang mai, không có tính đặc hiệu cao.
3. Trường hợp đặc biệt
Một số trường hợp đặc biệt mà mọi người nên lưu ý khi phương pháp xét nghiệm giang mai RPR cho kết quả sau đây:
- Dương tính giả: Xét nghiệm RPR dương tính giả thường xuất hiện khi người bệnh mắc viêm gan siêu vi B/C, bị bệnh tự miễn, bị HIV, phụ nữ đang mang thai, những người cao tuổi.
- Âm tính giả: Kết quả này xuất hiện khi bệnh giang mai ở giai đoạn đầu, lượng kháng thể chưa hình thành đủ để phát hiện nhiễm bệnh, hoặc bị giang mai ở giai đoạn muộn khi các kháng thể reagin đã giảm thấp, khó phát hiện được.
V. Lưu ý khi thực hiện xét nghiệm giang mai RPR
Để thực hiện xét nghiệm giang mai RPR hiệu quả thì mọi người cần lưu ý một số vấn đề sau đây:
- Chọn địa chỉ thực hiện xét nghiệm RPR uy tín để đảm bảo kết quả xét nghiệm chuẩn xác
- Tham khảo tư vấn bác sĩ, cung cấp đủ những thông tin cần thiết về các triệu chứng cơ thể gặp phải, loại thuốc sử dụng, bệnh lý mãn tính bởi các vấn đề này có thể ảnh hưởng đến kết quả xét nghiệm
- Tránh quan hệ không an toàn trước khi làm xét nghiệm để phòng ngừa nguy cơ lây nhiễm
- Không cần nhịn ăn trước khi làm xét nghiệm giang mai RPR
- Giữ tâm lý thoải mái để tránh ảnh hưởng đến huyết áp khi lấy máu làm xét nghiệm RPR
- Tuân thủ quy trình, hướng dẫn thực hiện làm xét nghiệm giang mai PRP để đảm bảo kết quả được chính xác
- Thực hiện thêm các xét nghiệm khác (xét nghiệm TPHA, VDRL) để đảm bảo kết quả chẩn đoán chuẩn xác bởi RPR không phải xét nghiệm đặc biệt và dễ cho kết quả dương tính/âm tính giả
- Sau khi xét nghiệm, nếu dương tính cần tuân thủ đúng phác đồ điều trị của bác sĩ, tái khám theo lịch hẹn

Hy vọng những chia sẻ trong bài viết này đã mang đến cho mọi người những thông tin hữu ích về phương pháp xét nghiệm giang mai RPR. Giang mai là bệnh lý cần được chẩn đoán sớm, điều trị đúng cách để tránh những biến chứng nguy hiểm ảnh hưởng xấu đến sức khỏe.

